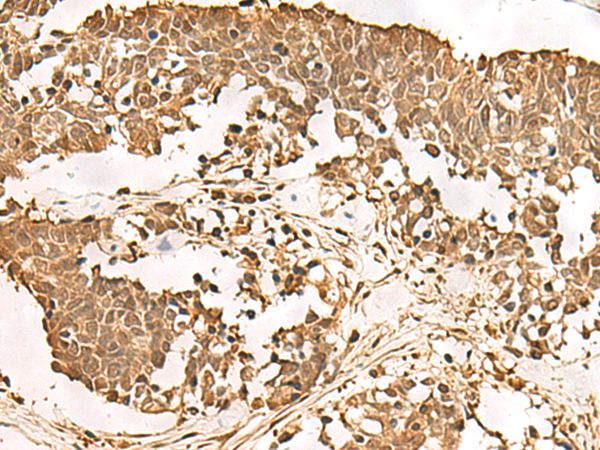

中文名稱: 兔抗PSMA3多克隆抗體
英文名稱: Anti-PSMA3 rabbit polyclonal antibody
別 名: proteasome subunit alpha 3; HC8; PSC3
相關(guān)類別: 一抗
儲 存: 冷凍(-20℃)
宿 主: Rabbit
抗 原: PSMA3
反應(yīng)種屬: Human, Mouse, Rat
標(biāo) 記 物: Unconjugate
克隆類型: rabbit polyclonal
技術(shù)規(guī)格
|
Background: |
The proteasome is a multicatalytic proteinase complex with a highly ordered ring-shaped 20S core structure. The core structure is composed of 4 rings of 28 non-identical subunits; 2 rings are composed of 7 alpha subunits and 2 rings are composed of 7 beta subunits. Proteasomes are distributed throughout eukaryotic cells at a high concentration and cleave peptides in an ATP/ubiquitin-dependent process in a non-lysosomal pathway. An essential function of a modified proteasome, the immunoproteasome, is the processing of class I MHC peptides. This gene encodes a member of the peptidase T1A family, that is a 20S core alpha subunit. Two alternative transcripts encoding different isoforms have been identified. |
|
Applications: |
ELISA, WB, IHC |
|
Name of antibody: |
PSMA3 |
|
Immunogen: |
Fusion protein of human PSMA3 |
|
Full name: |
proteasome subunit alpha 3 |
|
Synonyms: |
HC8; PSC3 |
|
SwissProt: |
P25788 |
|
ELISA Recommended dilution: |
5000-10000 |
|
IHC positive control: |
Human ovarian cancer and Human thyroid cancer |
|
IHC Recommend dilution: |
40-200 |
|
WB Predicted band size: |
28 kDa |
|
WB Positive control: |
NIH/3T3, A549, HL60 and PC3 cell, Mouse liver tissue, Mouse spleen tissue, Hela cell lysates |
|
WB Recommended dilution: |
500-2000 |

購物車
幫助
021-54845833/15800441009
